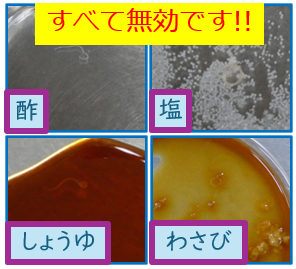
tyoumiryou

ホーム > くらし・安全・環境 > 身近な生活 > 食の安全・安心 > かながわの食の安全・安心 > アニサキスによる食中毒予防について
更新日:2026年2月12日
ここから本文です。
アニサキスの特徴や食中毒の予防方法について紹介しています。

アニサキスは寄生虫(線虫)の一種です。
アニサキスの幼虫は、サバ、アジ、サンマ、カツオ、イワシ、イカなど、様々な魚介類に寄生しています。
体長2~3cm、幅0.5~1mmほどの糸のような見た目をしており、肉眼で見ることができます。

アニサキスの幼虫が、人の体内で成虫になることはありません。
アニサキスが寄生した魚介類の刺身や、冷凍・加熱が不十分な魚介類の加工品が原因となります。

内臓部分では、赤丸で囲んだ部分のように、とぐろを巻いて寄生していることがあります。
(ブラックライト照射前)

(照射後)
身の部分では、内部に潜り込んで寄生していることがあります。一見するときれいな身に見えますが、ブラックライト(波長365nm)を当てると、虫体が青白く光って見えます。
人の胃や腸に入ったアニサキスの幼虫が組織に侵入すると、食中毒(アニサキス症)を引き起こします。
【胃アニサキス症】
食後数時間から十数時間後に、激しいみぞおちの痛み、嘔吐、悪心を生じます。
【腸アニサキス症】
食後数十時間から数日後に、激しい下腹部の痛み、腹膜炎症状を生じます。
これまでに、アニサキス食中毒による死亡例はありません。
アニサキスが抗原となりアレルギー反応を引き起こす、アニサキスアレルギーも報告されています。
アニサキスの幼虫は、主に内臓表面に寄生しており、漁獲後時間が経つにつれて身へ移行することがあります。そのため、内臓に近い腹側の身で見つかることが多いです。(背側の身で見つかることもあります。)
内臓に寄生する幼虫が漁獲後に身へ移行することがあるため、新鮮な魚介類を選び、なるべく早めに内臓を取り除きましょう。

魚介類を生(冷凍・加熱が不十分なものを含みます。)で食べる際には、アニサキスがいないかよく見て確認しましょう。
アニサキスを見つけた場合には、速やかに取り除きましょう。生ではなく加熱して食べると、さらに安心です。

(身に潜り込んだアニサキス)
【冷凍】-20℃以下で24時間以上の冷凍
【加熱】60℃で1分間以上又は70℃以上の加熱 が有効です。
一般的な料理で使う程度の調味料では効果がないので、酢〆、塩漬け、しょうゆ、わさびではアニサキスは死滅しません。

食品監視グループ
電話 045-285-0741
このページの所管所属は健康医療局 生活衛生部生活衛生課です。